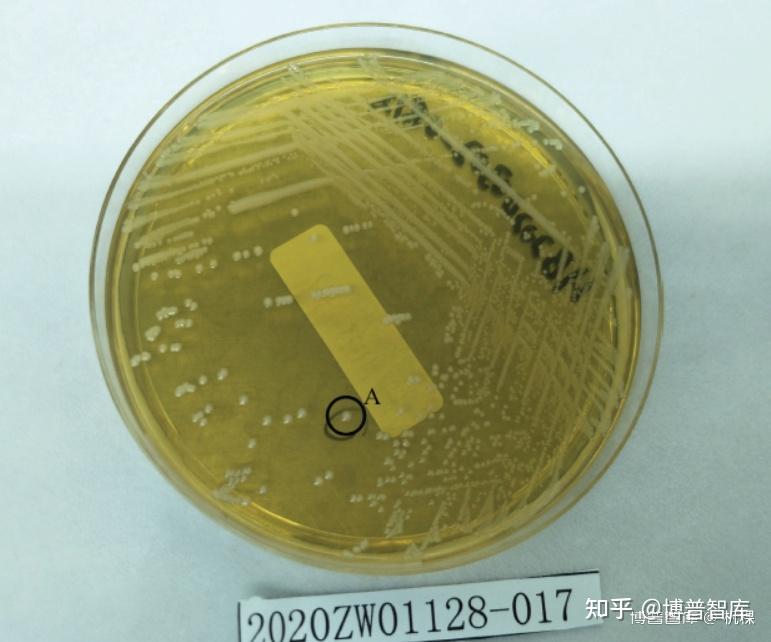
平板划线方法一般通过连续画蛇形曲线或四区划线方法进行.

接种环的使用方法图解

微生物的接种和培养
图片尺寸566x475
接种环反复灼烧要接种的细菌不会死吗
图片尺寸2000x1499
接种-
图片尺寸765x932
微生物检测常见接种方法操作要点汇总!
图片尺寸640x321
其操作步骤基本与斜面接种时相同,不同之处是挑取菌体的接种环放入
图片尺寸533x300
用右手先将棉塞拧转松动,再拿接种环,用右手的小指,无名指和手掌拨下
图片尺寸414x262
微生物检测常见接种方法操作要点汇总!
图片尺寸640x397
左手持斜面培养物,右手持接种环,按图 9 方法将接种环进行
图片尺寸1750x1086
画笔"接种环,超净台等工具和平台都需要经过高温或紫外线灭菌才能使用
图片尺寸640x427
可专业定制耐高温镍铬合金接种环
图片尺寸950x716
步骤③中,每次划线前后都需对接种环进行灼烧处理 d.
图片尺寸491x125
分区划线法 第一区划线 灭菌接种环 第二区划线 灭菌接种环 第三区
图片尺寸1080x810
几种常见的微生物接种方法介绍及其优缺点比较!
图片尺寸640x525
(2)接种技巧(1)取菌技巧3,无菌操作技术详细图解(7)消毒桶内消毒.
图片尺寸515x399
平板划线方法一般通过连续画蛇形曲线或四区划线方法进行.
图片尺寸771x642
此法即用灭菌的接种环挑取少量微生物菌种以呈等边三角形的三点点植于
图片尺寸1272x543
接种环的特点是什么,接种环的使用方法有哪些-元素商城
图片尺寸660x440
1ul接种环和bd接种环价格
图片尺寸681x817
以无菌操作用接种环直接取 平板上待分离纯化的菌落
图片尺寸669x649
微生物检验——细菌的接种方法
图片尺寸388x213
猜你喜欢:金属接种环微生物接种环图片接种环图片接种环安装方法及图片接种环平板划线法步骤图示万用表的使用方法图解前打竿的使用方法图解三脚架的使用方法图解冲洗器的使用方法图解微波炉的使用方法图解水准仪的使用方法图解复印机的使用方法图解调音台的使用方法图解袖扣使用方法图解全站仪使用方法图解靠尺使用方法图解电热水器使用方法图解消糜栓使用方法图解安全绳的使用方法八爪椅图解使用方法对讲机使用方法图解毛毛虫使用方法图解安全带的正确使用方法避孕套的正确使用方法使用方法万用表的使用方法肌肉贴使用方法图示显微镜的使用方法消防栓的使用方法等你图片壁纸究极奈克洛兹玛 形态香港大学logom5的螺纹心想事成文字图片拉珠式卷帘窗拆卸九代半雅阁尾灯墨西哥硬币玉桂狗的动画片聊天背景图片闺蜜三人单一个情字的图片qq狗头表情表情符号